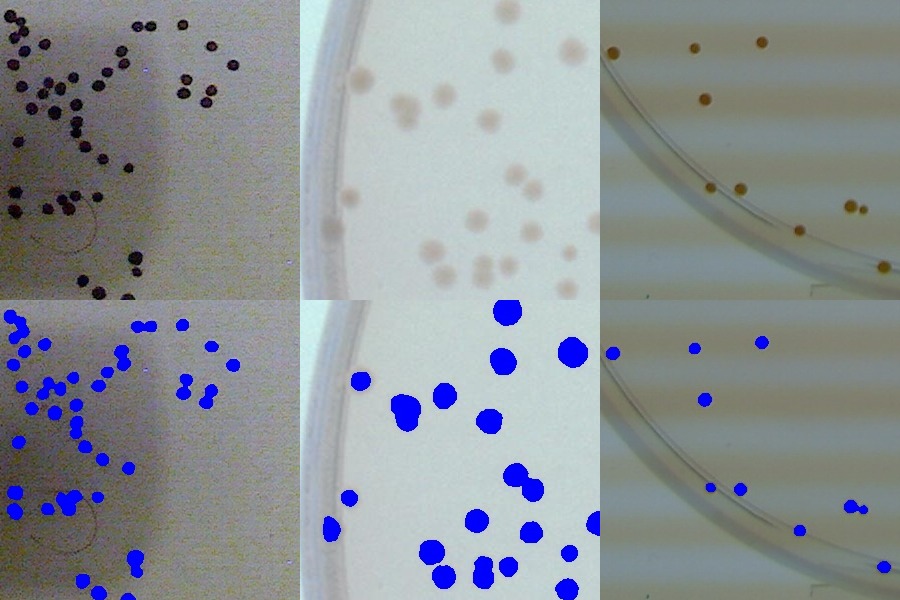
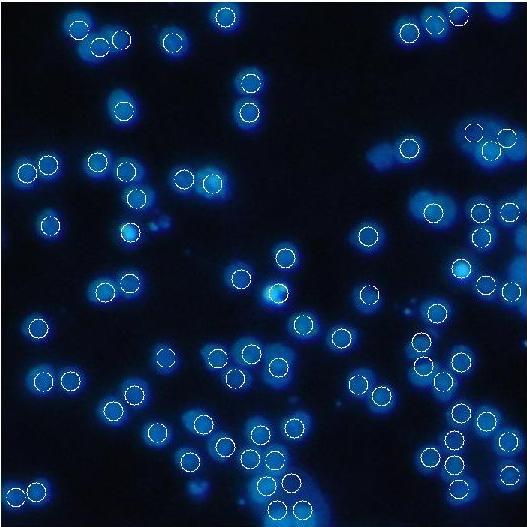

我一直在开发一个应用程序,用于从图片中计数圆形物体,如细菌菌落。
使它变得容易的是,物体通常与背景有很好的区别。
然而,很少有困难使分析变得棘手:
这一问题已在科学文献中多次得到解决,例如,使用圆形Hough变换或分水岭方法,但我从未对结果感到满意。
描述的一种简单方法是使用距离变换通过自适应阈值和分割(正如我在this post中所描述的)获得前景。
我已经成功地实现了这个方法,但它并不总是能处理强度的突然变化。另外,我也被同行们要求拿出一种更“新颖”的方法。
因此,I正在寻找一种提取前景的新方法.
因此,我研究了其他阈值/blob检测方法。我试过MSER,但发现在我的情况下,它们不太健壮,速度也很慢。
我最终提出了一种算法,到目前为止,它给了我很好的结果:
为了让你看到我必须要处理的那种形象:
这张图片代表了顶部的3个示例图像的一部分,以及底部各个部分的my算法(blue =前台)的结果。
以下是我的C++实现: 3-7
/*
* cv::Mat dst[3] is the result of the absolute difference between original and convolved channel.
* MCF(std::vector<cv::Point>, int, int) is a filter function that returns an positive int only if the input contour is valid.
*/
/* Allocate 3 matrices (1 per channel)*/
cv::Mat accu[3];
/* We define the maximal threshold to be tried as half of the absolute maximal value in each channel*/
int maxBGR[3];
for(unsigned int i=0; i<3;i++){
double min, max;
cv::minMaxLoc(dst[i],&min,&max);
maxBGR[i] = max/2;
/* In addition, we fill accumulators by zeros*/
accu[i]=cv::Mat(compos[0].rows,compos[0].cols,CV_8U,cv::Scalar(0));
}
/* This loops are intended to be multithreaded using
#pragma omp parallel for collapse(2) schedule(dynamic)
For each channel */
for(unsigned int i=0; i<3;i++){
/* For each value of threshold (m_step can be > 1 in order to save time)*/
for(int j=0;j<maxBGR[i] ;j += m_step ){
/* Temporary matrix*/
cv::Mat tmp;
std::vector<std::vector<cv::Point> > contours;
/* Thresholds dst by j*/
cv::threshold(dst[i],tmp, j, 255, cv::THRESH_BINARY);
/* Finds continous regions*/
cv::findContours(tmp, contours, CV_RETR_LIST, CV_CHAIN_APPROX_TC89_L1);
if(contours.size() > 0){
/* Tests each contours*/
for(unsigned int k=0;k<contours.size();k++){
int valid = MCF(contours[k],m_minRad,m_maxRad);
if(valid>0){
/* I found that redrawing was very much faster if the given contour was copied in a smaller container.
* I do not really understand why though. For instance,
cv::drawContours(miniTmp,contours,k,cv::Scalar(1),-1,8,cv::noArray(), INT_MAX, cv::Point(-rect.x,-rect.y));
is slower especially if contours is very long.
*/
std::vector<std::vector<cv::Point> > tpv(1);
std::copy(contours.begin()+k, contours.begin()+k+1, tpv.begin());
/* We make a Roi here*/
cv::Rect rect = cv::boundingRect(tpv[0]);
cv::Mat miniTmp(rect.height,rect.width,CV_8U,cv::Scalar(0));
cv::drawContours(miniTmp,tpv,0,cv::Scalar(1),-1,8,cv::noArray(), INT_MAX, cv::Point(-rect.x,-rect.y));
accu[i](rect) = miniTmp + accu[i](rect);
}
}
}
}
}
/* Make the global scoreMap*/
cv::merge(accu,3,scoreMap);
/* Conditional noise removal*/
if(m_minRad>2)
cv::medianBlur(scoreMap,scoreMap,3);
cvtColor(scoreMap,scoreMap,CV_BGR2GRAY);我有两个问题:
非常感谢你的帮助,
发布于 2012-07-24 14:37:53
几年前,我写了一个应用程序来检测显微镜图像中的细胞。代码是用Matlab编写的,我认为这比应该的复杂(这是我的第一个简历项目),所以我只会概述一些对你有帮助的技巧。顺便说一句,这是致命的慢,但它真的很好地分离大群的孪生细胞。
我定义了一种度量来评估给定的点是细胞中心的概率:-亮度在它周围的圆形图案中减少--纹理亮度的变化跟随一个给定的模式--一个单元将不会覆盖一个相邻单元的超过%。
使用它,我开始迭代地找到最好的单元格,标记为找到,然后查找下一个单元格。因为这样的搜索是昂贵的,所以我使用了遗传算法在我的特征空间中进行更快的搜索。
以下是一些结果:

https://stackoverflow.com/questions/11631188
复制相似问题